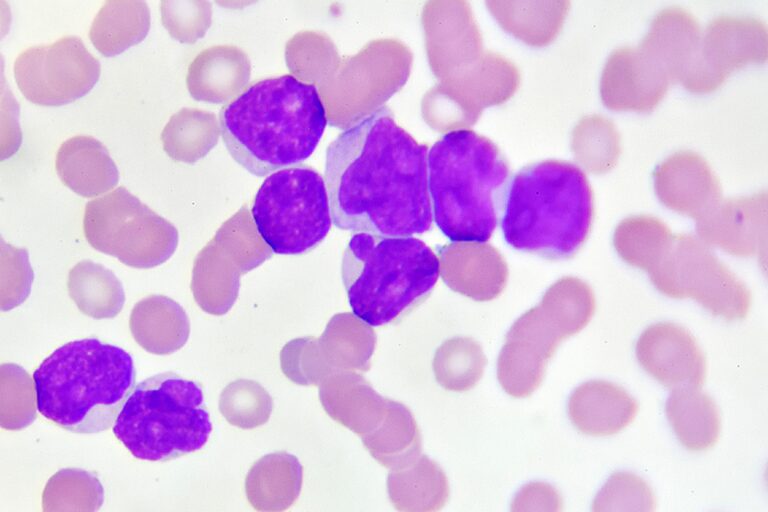
Leucemia mieloide acuta, una nuova cura in compresse riduce il rischio ricadute 3

Cos’è l’azacitidina? Si aprono nuovi orizzonti per la cura della leucemia mieloide acuta. Dopo 30 anni in cui l’unica cura disponibile era la chemioterapia, efficace purtroppo solo in parte, a far ben sperare sono alcune soluzioni innovative arrivate negli ultimi 5 anni.
La leucemia mieloide acuta, che è la malattia che è costata la vita a Sinisa Mihajlovic, è infatti una neoplasia molto aggressiva e difficile da combattere, soprattutto a causa delle frequenti recidive. Proprio per ridurre i rischi di ricaduta, l’Agenzia Italiana del Farmaco (Aifa) ha approvato una nuova terapia di mantenimento, chiamata azacitidina.
Azacitidina, come funziona e a chi è destinata la nuova terapia contro la leucemia
Azacitidina è una nuova terapia di riferimento in grado di ridurre il pericolo che la leucemia mieloide acuta si ripresenti e che, quindi, può allungare la speranza di vita dei malati che non riescono a sottoporsi a un trapianto.
Un’innovazione fondamentale, se si pensa pure che spesso il trapianto di midollo da donatore – che è ancora la soluzione più efficace – risulta spesso impraticabile anche per via dell’età avanzata dei pazienti, che non tollererebbero una procedura così pesante.
L’azacitidina orale risulta in questo senso molto utile, anche se resta una terapia di mantenimento destinata solo a pazienti che abbiano conseguito una remissione completa (o remissione completa con recupero incompleto dell’emocromo) dopo la terapia d’induzione associata o meno a trattamento di consolidamento e che non siano candidabili al trapianto di cellule staminali emopoietiche.
Azacitidina, l’esperto: “Aumenta la sopravvivenza globale e la possibilità di sopravvivenza libera da recidiva”
Fabrizio Pane, professore Ordinario di Ematologia e Direttore dell’Unità Operativa di Ematologia e Trapianti di Midollo all’Università Federico II di Napoli, ha sottolineato come azacitidina sia “la prima terapia orale di mantenimento che ha dimostrato di aumentare la sopravvivenza globale e ha mostrato un beneficio di sopravvivenza libera da recidiva nei pazienti con leucemia mieloide acuta”.
Nello specifico, il professor Pane ha spiegato: “Nello studio internazionale QUAZAR AML-001, pubblicato sul New England Journal of Medicine, che ha arruolato 472 pazienti, la sopravvivenza globale mediana era superiore a due anni (24,7 mesi) nei pazienti trattati con azacitidina orale rispetto a 14,8 mesi con placebo. Anche la sopravvivenza libera da recidiva mediana è risultata significativamente più lunga con azacitidina orale e ha raggiunto 10,2 mesi rispetto a 4,8 mesi del braccio di controllo”.
Senza contare che – essendo la cura in compresse – è anche molto agevole da assumere per persone che sono in remissione completa e che necessitano di una buona qualità di vita.
Cos’è la leucemia mieloide acuta
La leucemia mieloide acuta è un tumore del sangue che colpisce ogni anno circa 3.500 persone in Italia. Ad ammalarsi sono soprattutto gli anziani, ma questo non esclude che possa manifestarsi anche nei bambini.
La malattia ha origine nelle cellule staminali presenti nel midollo osseo. Queste ultime si sviluppano in modo incontrollato e molto rapidamente, motivo per cui questa leucemia si definisce acuta. Si tratta di un tumore molto aggressivo. Secondo le statistiche, a cinque anni dalla diagnosi sopravvive solo il 35-40% dei pazienti.
Leggi anche: Padova, nipoti salvano la vita alla zia con un doppio trapianto di fegato: “Prima volta in Europa”

